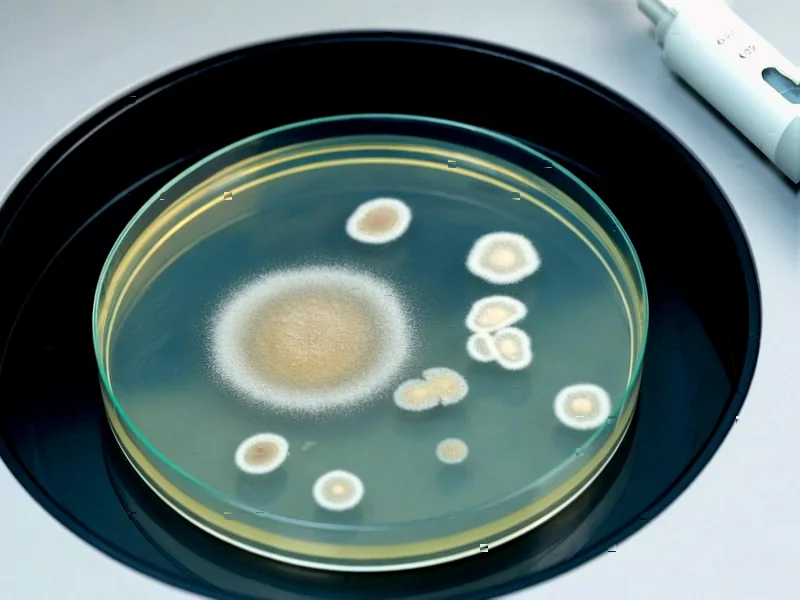
Bacteria's Clever Counterattack: Silencing Drug-Bound Riboso - According to Nature, researchers have identified a sophisticat

OpenAI Announces $25 Billion Argentina Data Center Project in Patagonia
OpenAI has entered into an agreement with Sur Energy to build a massive 500-megawatt data center in Argentina’s Patagonia region. The $25 billion project represents one of the largest investments in the country’s history and signals OpenAI’s aggressive global AI infrastructure expansion. The facility will support the company’s growing computing needs as it dominates the artificial intelligence market.
OpenAI is making waves in the global technology landscape with its planned $25 billion data center project in Argentina, marking one of the most significant foreign investments in the South American nation’s history. The ChatGPT creator has partnered with energy developer Sur Energy to establish a massive 500-megawatt facility in the Patagonia region, according to Friday’s announcement from the Argentine government. This monumental project underscores the rapid global expansion of OpenAI as it races to secure the computing infrastructure needed to maintain its leadership in the competitive artificial intelligence sector.